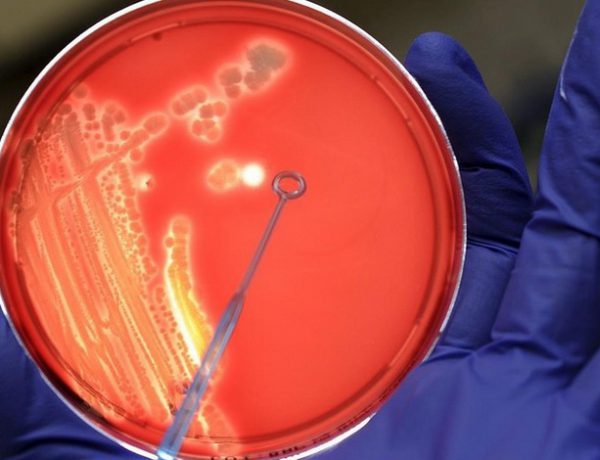

Dirigentes políticos, familiares y amigos dijeron presente en Casa de Gobierno. Los restos del tres veces gobernador …
1-1
La Volvo XC60 había sido declarada el Automóvil del Año en el salón de Nueva York
Coincidencias del destino, la camioneta en la que viajaba José Manuel De la Sota, una Volvo XC60, que impactó de fren…
Descartaron tres de los últimos cinco contactos del Ara San Juan
El Seabed Constructor descartó tres de los últimos cinco contactos encontrados por los Vehículos Autónomos Submarinos…
Una nueva marcha al cumplirse 1 año y tres meses del hundimiento del Repunte
En el marco del cumplimiento de un año y tres meses del hundimiento del buque marplatense Repunte, familiares de los …
Alerta a lo largo y ancho del país por la bacteria Streptococcus pyogenesen que ya ha matado a seis personas
Seis personas han fallecido en el país por la bacteria Streptococcus pyogenesen los últimos días, entre ellas cinco …
Marcha multisectorial en defensa de la educación pública, gratuita y de calidad
Este miércoles 12 de septiembre se realizará en Mar del Plata una Marcha multisectorial en defensa de la educación pú…
En su Día los maestros tienen un 50% de descuento en indumentaria con el Banco Provincia
El Banco Provincia anunció una promoción especial para celebrar el Día del Maestro este 11 de septiembre. El benefici…
El Municipio firmó convenio con la Suprema Corte de Justicia por los títulos ejecutivos
El intendente Carlos Fernando Arroyo suscribió un importante convenio de colaboración tecnológica con la Suprema Cort…
Panaderos junto al Intendente lanzaron el programa “Pan Social” a $ 39.50 el kilo
Luego de los aumentos en el precio de la harina, el intendente Carlos Arroyo implementó este lunes el programa “Pan S…
Arroyo firma convenio en busca de garantizar el kilo de pan a un precio accesible
Junto al Centro Industrial de Panaderos y la Federación de Industria Panaderil de la Provincia, la comuna busca garan…